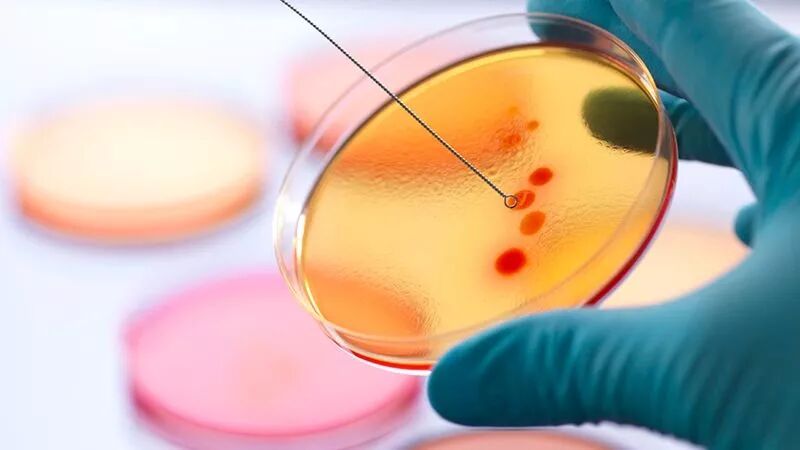

图为2006年3月,乌克兰的一家医院中,年仅5岁的白血病患儿阿纳斯塔西娅。她的嘴角涂着治疗真菌感染的绿色药水。
2010年,宾夕法尼亚大学的免疫学家布鲁斯·莱文(Bruce Levine)和卡尔·朱恩(Carl June)等待着一项试验结果。他俩新发明的癌症疗法被用于三名病人,他们患有尚无药物可以治疗的淋巴性白血病。而这种CAR-T细胞疗法的工作原理是:从病人体内提取免疫细胞T淋巴细胞,放到实验室内进行基因修饰,使之靶向癌细胞,然后重新将其注入病人体内,使之发挥作用。
结果揭晓了,区区一剂药就消灭了两位病人体内的白血病,摧毁了成斤的癌细胞。第三位病人出现了部分响应,但后来去世了。不过,另两人却摆脱了癌症。当时,莱文和朱恩开发CAR-T细胞疗法已经有十多个年头,在这十多年里,科学界的同行曾不断地投来怀疑的目光。“在别人眼里,我们的工作很小众,”莱文说。他在宾夕法尼亚大学佩雷尔曼医学院工作。由于没有经费在其他患者身上进行测试,他们大胆决定发表已有的结果,于是在2011年,一石激起千层浪,“局面发生了迅速而又剧烈的转变,”莱文说。

快进到2017年,美国食品药品监督管理局(FDA)做出里程碑式的决定:批准两种使用CAR-T细胞疗法(即将基因修饰的免疫细胞注射入病人体内)的“药物”用于造血与淋巴组织肿瘤的治疗。FDA先是在2017年8月批准了Kymriah——诺华制药(Novartis)用于治疗儿童和青少年急性淋巴细胞白血病的疗法,当年10月又批准了Yescarta——吉利德科学公司(Gilead Sciences)用于治疗成人弥漫性大B细胞淋巴瘤的疗法。它们是最先获得FDA批准的基因疗法,也由此创造了历史。“对我们来说,这是职业生涯中的一个亮点,但对病人来说,其意义就大了。”
FDA的决定开启了个性化癌症疗法的新时代。
CAR-T疗法使用了病人的自体细胞,因此排异可能性较低。而且,因为是一次性注射,它也避开了化疗等其他癌症疗法需要多轮治疗的问题。其副作用更少一些,疗效的持久性也得到证明:
今年2月发布的Kymriah临床试验结果显示,接受治疗后,76%的癌症病人存活了一年以上,这是其他疗法未曾企及的。
由于精准地靶向恶性细胞,CAR-T细胞“在治疗造血与淋巴组织肿瘤方面,有着其他疗法无法比拟的疗效,”莱文说。

这种疗法部分源于莱文早期的HIV研究。1992年,在攻读免疫学和传染病学博士期间,他读到了卡尔·朱恩有关T细胞信号的研究:当时的朱恩正成为合成生物学领域的先锋。莱文加入朱恩在马里兰州贝塞斯达的海军医学研究所的实验室,开始了一个项目:
在实验室内培养健康的免疫细胞,然后将其注入HIV感染者的体内。他们证明,这种手段可以促进病人的免疫功能,并意识到,只要稍加调整,它也能用于癌症治疗。
癌症的棘手之处在于,它能侵入免疫系统——或抑制其防御机制;或乔装打扮,避开监视。为攻克这一难关,莱文和朱恩开始跟Cell Genesys公司协作,修饰T细胞,使之囊括某些特定的基因,通过基因表达,产生靶向恶性组织的专门受体。
这些受体名为嵌合抗原受体(Chimeric Antigen Receptor,简称CAR),经修饰之后,可以靶向CD19——造血与淋巴组织肿瘤(如白血病和淋巴癌)的癌细胞上常有的一种抗原。
“通过这种方法,你可以重定向免疫细胞的特异性。”莱文说。“从某种意义上讲,我们对T细胞进行调教,让它能看到平时看不到的东西,”一旦在实验室中复制出来,并被释放到病人体内,这些经修饰的CART-T细胞就能迅速定位恶性细胞,与之结合,并将其摧毁。

到目前为止,这种疗法主要都是针对造血与淋巴组织肿瘤,因为像急性淋巴细胞白血病等疾病,其发病人群都是儿童,从道德上讲,是一种义不容辞的责任。但其背后也有比较现实的原因:
造血与淋巴组织肿瘤的DC19抗原为那些T细胞提供了一个明确的靶标,但在其他癌症中,这些靶标就没那么明确了。要么癌细胞抗原在健康组织中也有表达,敌友难分,不可不慎;要么因为是实体瘤,抗原被重重包裹,使T细胞难以渗透。
攻克这些难关是CAR-T细胞疗法的新战线。
莱文预言,下一步,FDA将批准针对骨髓瘤的疗法,目前,这类疗法正在开发之中。再接下去将是针对实体瘤的疗法。“很多研究团队,包括我们,都在致力于实体瘤疗法的研发,”这包括胰腺癌、卵巢癌、乳腺癌和前列腺癌,他说。针对造血与淋巴组织肿瘤的疗法也需要进一步完善:在存活一年以上的病人中,半数仍会在那一期间复发。目前,莱文和同事们正试图找出其他可充当靶标的抗原,以拓展T细胞的攻击视野。
但未来,最大的挑战是将CAR-T细胞疗法的成本降下来,莱文说。Kymriah和Yescarta一次注射的费用分别是47.5万美元和37.3万美元。“它们是定制疗法;取自病人,并用于同一个病人。因此,不是说把一个1升的生物反应器扩容到5000升就完了,”莱文说。
要惠及更多人,就必须降低其成本。莱文认为,随着越来越多的基因疗法被开发出来,生产方式的变革也将应运而生。“工程方面的难关就是将这些纳米级的生产技术自动化,这样就能治疗更多的病人,尤其是涉及到发病率更高的疾病时,比如淋巴癌和骨髓癌,当然还有实体瘤,”他说。
眼下,莱文正与众多研究中心合作,以加速疗法的生产过程。和所有伟大的理念一样,它需要耗费时日才能成为现实,他说。但这并没有阻止莱文的脚步。